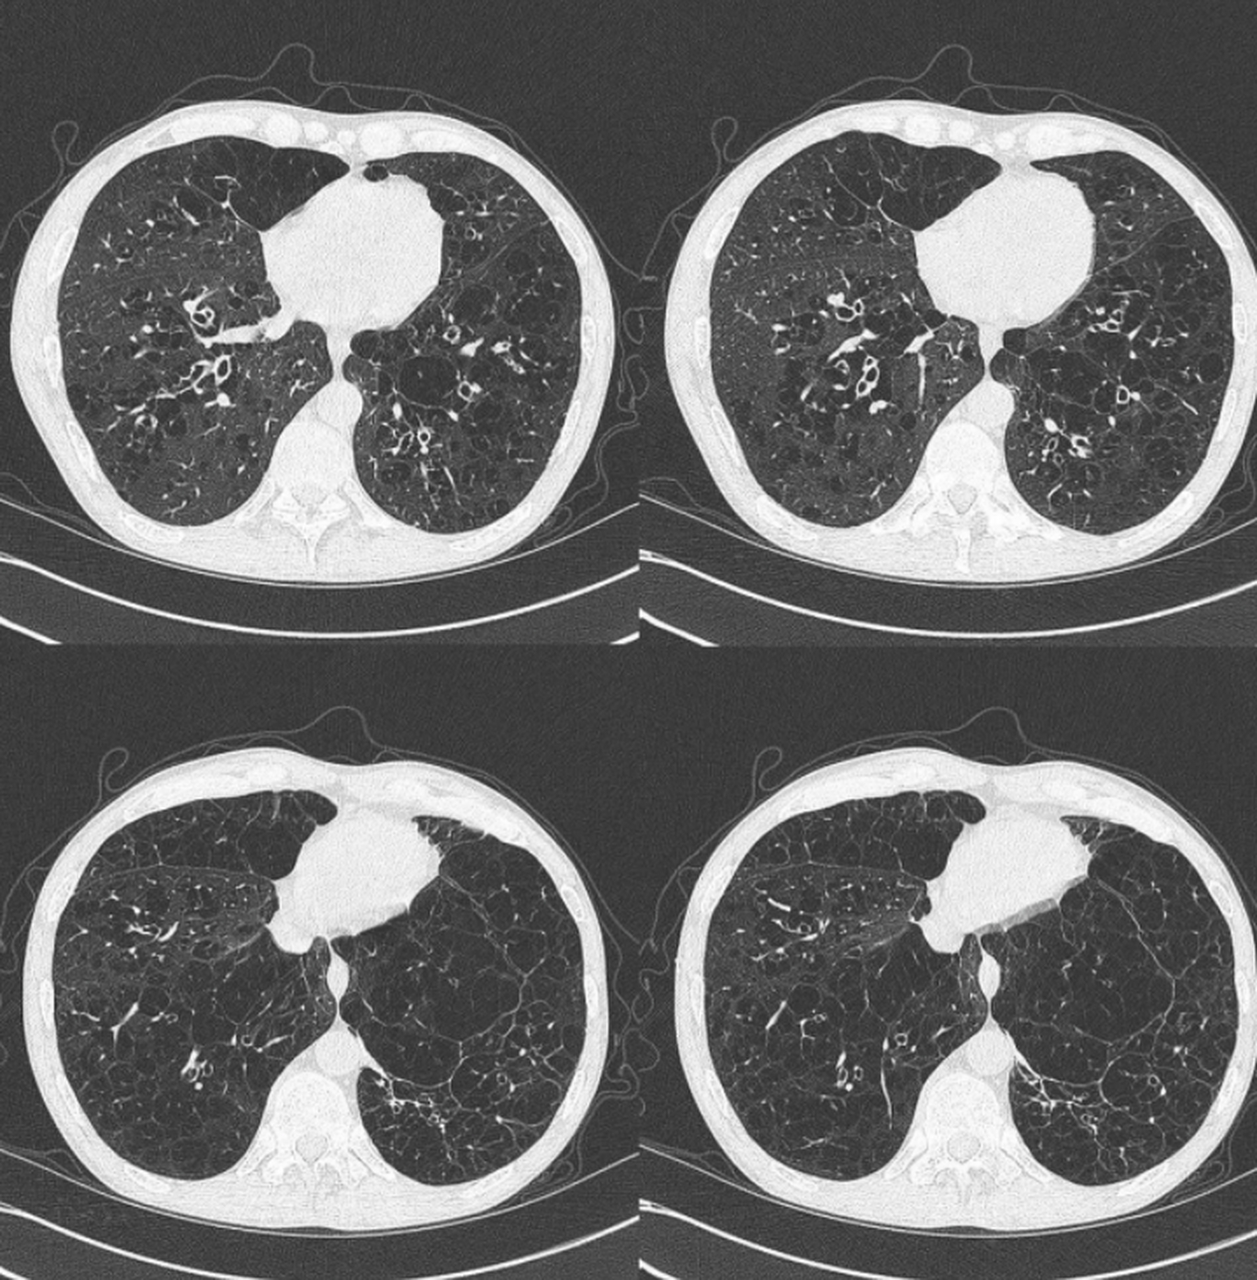
选择用中医药来治疗肺结节,肺气肿,肺大泡,慢阻肺,到底是不是交智商税

慢阻肺ct图片 肺部

满目疮痍→记录一例慢阻肺合并ipa的疑问 - 丁香园论坛
图片尺寸4096x3072
选择用中医药来治疗肺结节,肺气肿,肺大泡,慢阻肺,到底是不是交智商税
图片尺寸1257x1280
慢阻肺也称其为慢性阻塞性肺病,它是肺部疾病的一个总称
图片尺寸2000x1333
肺气肿ct分型
图片尺寸2028x1280
慢性阻塞性肺疾病 急性加重期.
图片尺寸3024x4032
慢阻肺背景下的肺炎
图片尺寸4624x3468
满目疮痍→记录一例慢阻肺合并ipa的疑问 - 丁香园论坛
图片尺寸4096x3072
满目疮痍→记录一例慢阻肺合并ipa的疑问 - 丁香园论坛
图片尺寸4096x3072
烟龄40多年,每天不到一包,不咳不喘,极轻度的慢支肺气肿患者的肺ct#给
图片尺寸1610x1280
拿什么来拯救你一营养不良的慢阻肺
图片尺寸4096x3072
满目疮痍→记录一例慢阻肺合并ipa的疑问 - 丁香园论坛
图片尺寸4096x3072
经过查看患者病历,细致询问病史,再结合其肺部 ct,肺功能,血常规等
图片尺寸970x827
满目疮痍→记录一例慢阻肺合并ipa的疑问 - 丁香园论坛
图片尺寸4096x3072
男性80岁既往慢阻肺病史以下是胸片各位老师指点一下
图片尺寸4000x3000
慢阻肺,在肺ct上能看出来吗?
图片尺寸1080x673
慢阻肺来临前,会先经历3个症状!劝告:一旦出现,别轻易忽视了
图片尺寸640x605
满目疮痍→记录一例慢阻肺合并ipa的疑问 - 丁香园论坛
图片尺寸4096x3072
烟龄40多年,每天不到一包,不咳不喘,极轻度的慢支肺气肿患者的肺ct#给
图片尺寸1246x1280
烟龄40多年,每天不到一包,不咳不喘,极轻度的慢支肺气肿患者的肺ct#给
图片尺寸1401x1280
病例 | 流感病毒感染致老年慢性阻塞性肺病急性加重1例
图片尺寸863x788